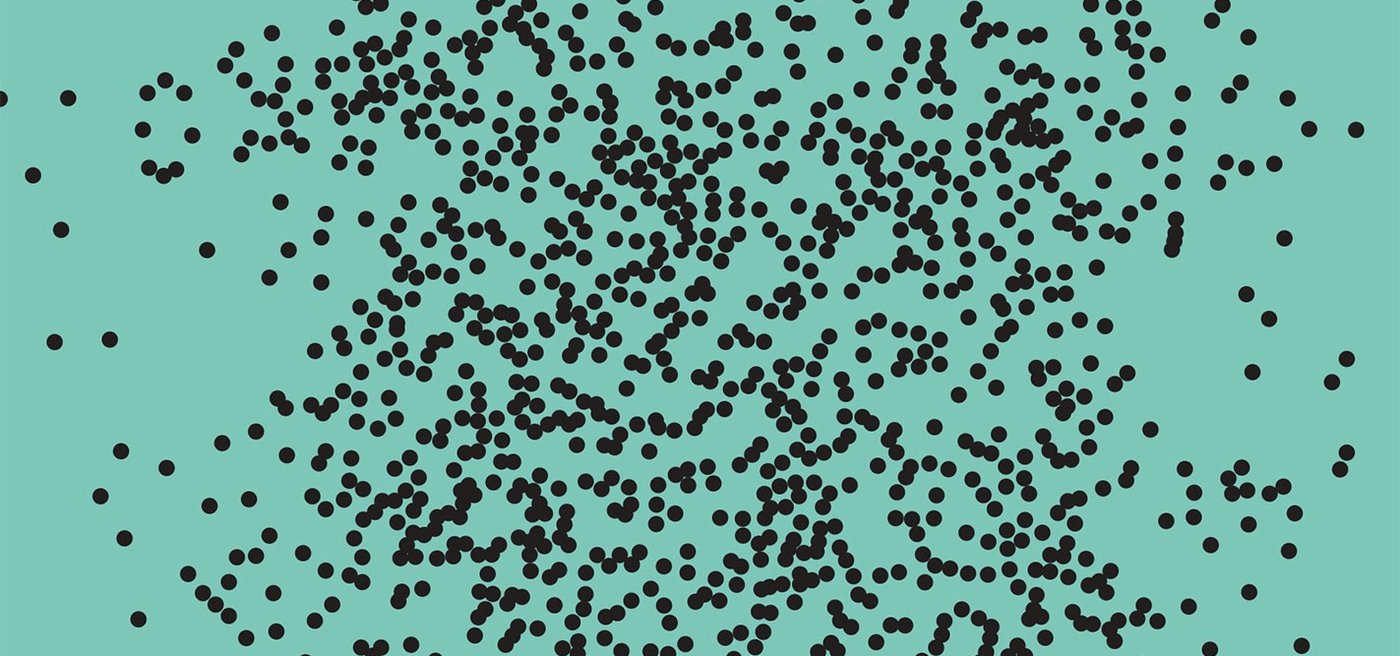

Erik Martiniussen has just published his new book The War against Bacteria to critical acclaim from a collective Norwegian Press. With two newspapers giving it the highest score possible, 6 out of 6, and the third calling it one of the best books of the year (already) – this surely is a fantastic launch.
Here’s what the press has written about the book so far:
Dagbladet (6 out of 6):
“Page-turner about the silent plague. The impressive The War against Bacteria is scary reading, but no dystopia.…He impresses with his clarity, thoroughness and the huge amount of substance – and not at least the linguistic clarity that makes the book easily readable for everyone.”
Aftenposten:
“Already now in March I can say: This book about bacteria is one of the best of the year!…I bow in the germ-filled dust of writer and journalist Erik Martiniussen and his hunt for bacteria. This is a great book about some of our smallest enemies and friends.”
Stavanger Aftenblad (6 out of 6):
“He has written a sober book where the facts speak for themselves. He does this without frightening adjectives but relies on the drama of the material to be strong enough to hold on to the reader. And he approaches his interviewees with an open, curious mind, and with no fixed opinions. The result is natural science research journalism of the highest class.”
Dagens Næringsliv:
“If you don’t think the corona pandemic is frightening enough, Erik Martiniussen convinces with a highly up-to-date book about the growing danger of resistant bacteria.”